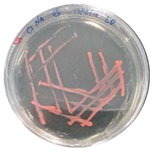
Heritage 06 00331 i008
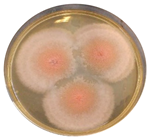
Heritage 06 00331 i010
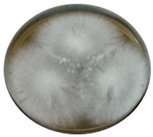
Heritage 06 00331 i014
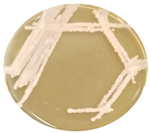
Heritage 06 00331 i016

Unveiling the Effectiveness of Innovative Commercial Coatings Used for the Preservation of Natural Stone—A Contribution
Abstract
:1. Introduction
2. Materials and Methods
2.1. Experimental Setup and Preparation of the Stone Mock-Ups
2.2. Preparation of the Cells’ Suspensions
2.3. Compatibility of the Coatings and Their Effectiveness against UV Radiation and Water Action
2.4. Antimicrobial Potential of the Coatings
2.4.1. Assessing the Antimicrobial Potential Using the Disk Diffusion Method
2.4.2. Assessing the Antimicrobial Potential on Stone Mock-Ups
3. Results and Discussion
3.1. Compatibility of the Coatings and Their Effectiveness against Water Action and UV Radiation
3.2. Antimicrobial Potential on Agar Plates
3.3. Antimicrobial Potential on Stone Mock-Ups
4. Conclusions
Supplementary Materials
Author Contributions
Funding
Data Availability Statement
Acknowledgments
Conflicts of Interest
References
- Nasri, F.; Boumezbeur, A.; Benavente, D. Influence of the petrophysical and durability properties of carbonate rocks on the deterioration of historic constructions in Tebessa (northeastern Algeria). Bull. Eng. Geol. Env. 2019, 78, 3969–3981. [Google Scholar] [CrossRef]
- Padilla-Ceniceros, R.; Pacheco-Martínez, J.; López-Doncel, R.A.; Orenday-Tapia, E.E. Rock deterioration in the masonry walls of the Cathedral Basilica of Aguascalientes, Mexico. Rev. Mex. Cienc. Geol. 2017, 34, 138–149. [Google Scholar] [CrossRef]
- Dias, L.; Rosado, T.; Candeias, A.; Mirão, J.; Caldeira, A.T. A change in composition, a change in colour: The case of limestone sculptures from the Portuguese National Museum of Ancient Art. J. Cult. Herit. 2020, 42, 255–262. [Google Scholar] [CrossRef]
- Rosado, T.; Dias, L.; Lança, M.; Nogueira, C.; Santos, R.; Martins, M.R.; Candeias, A.; Mirão, J.; Caldeira, A.T. Assessment of microbiota present on a Portuguese historical stone convent using high-throughput sequencing approaches. MicrobiologyOpen 2020, 9, e1030. [Google Scholar] [CrossRef]
- Ershad-Langroudi, A.; Fadaei, H.; Ahmadi, K. Application of polymer coatings and nanoparticles in consolidation and hydrophobic treatment of stone monuments. Iran. Polym. J. 2019, 28, 1–19. [Google Scholar] [CrossRef]
- Ortega-Morales, O.; Montero-Muñoz, J.L.; Baptista Neto, J.A.; Beech, I.B.; Sunner, J.; Gaylarde, C. Deterioration and microbial colonization of cultural heritage stone buildings in polluted and unpolluted tropical and subtropical climates: A meta-analysis. Int. Biodeterior. Biodegrad. 2019, 143, 104734. [Google Scholar] [CrossRef]
- Frigione, M.; Lettieri, M. Novel Attribute of Organic–Inorganic Hybrid Coatings for Protection and Preservation of Materials (Stone and Wood) Belonging to Cultural Heritage. Coat 2018, 8, 319. [Google Scholar] [CrossRef]
- Kanellopoulou, D.G.; Koutsoukos, P.G. Kinetics of Dissolution of Monument Building Materials. In 10th International Symposium on the Conservation of Monuments in the Mediterranean Basin: Natural and Anthropogenic Hazards and Sustainable Preservation; Koui, M., Zezza, F., Kouis, D., Eds.; Springer: Cham, Switzerland, 2018; pp. 339–346. [Google Scholar] [CrossRef]
- Cappelletti, G.; Fermo, P. 15—Hydrophobic and superhydrophobic coatings for limestone and marble conservation. In Smart Composite Coatings and Membranes; Montemor, M.F., Ed.; Woodhead Publishing: Sawston, UK, 2016; pp. 421–452. [Google Scholar] [CrossRef]
- Alves, C.; Figueiredo, C.A.M.; Sanjurjo-Sánchez, J.; Hernández, A.C. Salt weathering of natural stone: A review of comparative laboratory studies. Heritage 2021, 4, 1554–1565. [Google Scholar] [CrossRef]
- Raju, K.; Ravindhar, S. Detailed review on natural stone materials in architecture. Mater. Today Proc. 2021, 45, 6341–6347. [Google Scholar] [CrossRef]
- Schroer, L.; Boon, N.; De Kock, T.; Cnudde, V. The capabilities of bacteria and archaea to alter natural building stones—A review. Int. Biodeterior. Biodegrad. 2021, 165, 105329. [Google Scholar] [CrossRef]
- Pinheiro, A.C.; Mesquita, N.; Trovão, J.; Soares, F.; Tiago, I.; Coelho, C.; Paiva de Carvalho, H.; Gil, F.; Catarino, L.; Piñar, G.; et al. Limestone biodeterioration: A review on the Portuguese cultural heritage scenario. J. Cult. Herit. 2019, 36, 275–285. [Google Scholar] [CrossRef]
- Zhang, H.; Liu, Q.; Liu, T.; Zhang, B. The preservation damage of hydrophobic polymer coating materials in conservation of stone relics. Prog. Org. Coat. 2013, 76, 1127–1134. [Google Scholar] [CrossRef]
- Ema, N.P.; Álvarez de Buergo, M. Adverse effects arising from conservation treatments on archaeological sites: Theory, practice and review. Coalition 2013, 24, 14–23. [Google Scholar]
- Delgado-Rodrigues, J. Stone patina: A controversial concept of relevant importance in conservation. In Proceedings of the International Seminar Theory and Practice in Conservation: A Tribute to Cesare Brandi, Lisbon, Portugal, 4–5 May 2006; LNEC: Lisbon, Portugal, 2006; Volume 1, pp. 163–174. [Google Scholar]
- Corcione, C.E.; Striani, R.; Capone, C.; Molfetta, M.; Vendetta, S.; Frigione, M. Preliminary study of the application of a novel hydrophobic photo-polymerizable nano-structured coating on concrete substrates. Prog. Org. Coat. 2018, 121, 182–189. [Google Scholar] [CrossRef]
- Raneri, S.; Barone, G.; Mazzoleni, P.; Alfieri, I.; Bergamonti, L.; De Kock, T.; Cnudde, V.; Lottici, P.P.; Lorenzi, A.; Predieri, G.; et al. Efficiency assessment of hybrid coatings for natural building stones: Advanced and multi-scale laboratory investigation. Constr. Build. Mater. 2018, 180, 412–424. [Google Scholar] [CrossRef]
- Colangiuli, D.; Lettieri, M.; Masieri, M.; Calia, A. Field study in an urban environment of simultaneous self-cleaning and hydrophobic nanosized TiO2-based coatings on stone for the protection of building surface. Sci. Total Environ. 2019, 650, 2919–2930. [Google Scholar] [CrossRef]
- Cappelleti, G.; Fermo, P.; Camiloni, M. Smart hybrid coatings for natural stones conservation. Prog. Org. Coat. 2015, 78, 511–516. [Google Scholar] [CrossRef]
- Kapridaki, C.; Maravelaki-Kalaitzaki, P. TiO2-SiO2-PDMS nano-composite hydrophobic coating with self-cleaning properties for marble protection. Prog. Org. Coat. 2013, 76, 400–410. [Google Scholar] [CrossRef]
- Berdimurodov, E.; Berdimuradov, K.; Eliboev, I.; Kholikov, A.; Akbarov, K.; Umirov, N.; Borikhonov, B. Chapter 12: Smart-hybrid nanomaterials in corrosion prevention. In Corrosion Prevention Nanoscience: Nanoengineering Materials and Technologies; Tukhlievich, B.E., Verma, C., Eds.; De Gruyter: Berlin, Germany; Boston, MA, USA, 2023; pp. 181–194. [Google Scholar] [CrossRef]
- Sierra-Fernandez, A.; Gomez-Villalba, L.; Rabanal, M.; Fort, R. New nanomaterials for applications in conservation and restoration of stony materials: A review. Mater. Construcción 2017, 67, 107. [Google Scholar] [CrossRef]
- Luna, M.; Mosquera, M.J.; Vidal, H.; Gatica, J.M. Au-TiO2/SiO2 photocatalysts for building materials: Self-cleaning and de-polluting performance. Build. Environ. 2019, 164, 106347. [Google Scholar] [CrossRef]
- Franco-Castillo, I.; Hierro, L.; de la Fuente, J.; Seral-Ascaso, A.; Mitchell, S.G. Perspectives for antimicrobial nanomaterials in cultural heritage conservation. Chem 2021, 7, 629–669. [Google Scholar] [CrossRef]
- Dias, L.; Rosado, T.; Coelho, A.; Barrulas, P.; Lopes, L.; Moita, P.; Candeias, A.; Mirão, J.; Caldeira, A.T. Natural limestone discolouration triggered by microbial activity—A contribution. AIMS Microbiol. 2018, 4, 594–607. [Google Scholar] [CrossRef] [PubMed]
- Miller, A.Z.; Laiz, L.; Gonzalez, J.M.; Dionísio, A.; Macedo, M.F.; Saiz-Jimenez, C. Reproducing stone monument photosynthetic-based colonization under laboratory conditions. Sci. Total Environ. 2008, 405, 278–285. [Google Scholar] [CrossRef]
- Cappitelli, F.; Principi, P.; Pedrazzani, R.; Toniolo, L.; Sorlini, C. Bacterial and fungal deterioration of the Milan Cathedral marble treated with protective synthetic resins. Sci. Total Environ. 2007, 385, 172–181. [Google Scholar] [CrossRef] [PubMed]
- M02-A11; Performance Standards for Antimicrobial Disk Susceptibility Tests: Approved Standard, 11th ed. Clinical and Laboratory Standards Institute (CLSI): Wayne, PA, USA, 2012.
- Munafò, P.; Battista Goffredo, G.; Quagliarini, E. TiO2-based nanocoatings for preserving architectural stone surfaces: An overview. Constr. Build. Mater. 2015, 84, 201–218. [Google Scholar] [CrossRef]
- Lisci, C.; Sitzia, F.; Pires, V.; Mirão, J. Building stones durability by UVA radiation, moisture and spray accelerated weathering. J. Build. Pathol. Rehabil. 2022, 7, e60. [Google Scholar] [CrossRef]
- Careddu, N.; Graziella, M. The effects of solar UV radiation on the gloss values of polished stone surfaces. Constr. Build. Mater. 2013, 49, 828–834. [Google Scholar] [CrossRef]
- Jia, Z.; Hong, R. Anticorrosive and photocatalytic properties research of epoxy-silica organic-inorganic coating. Colloids Surf. A Physicochem. Eng. Asp. 2021, 622, 126647. [Google Scholar] [CrossRef]
- Al Zoubi, W.; Prisla Kamil, M.; Fatimah, S.; Nashrah, N.; Gun Ko, Y. Recent advances in hybrid organic-inorganic materials with spatial architecture for state-of-the-art applications. Prog. Mater. Sci. 2020, 112, 100663. [Google Scholar] [CrossRef]
- El-Bashir, S.M.; Yahia, I.S.; Al-Harbi, F.; Elburaih, H.; Al-Faifi, F.; Aldosari, N.A. Improving photostability and efficiency of polymeric luminescent solar concentrations by PMMA/MgO nanohybrid coatings. Int. J. Green Energy 2017, 14, 270–278. [Google Scholar] [CrossRef]
- Kumar, D.; Wu, X.; Fu, Q.; Chye Ho, J.W.; Kanhere, P.D.; Li, L.; Chen, Z. Development of durable self-cleaning coatings using organic-inorganic hybrid sol-gel method. Appl. Surf. Sci. 2015, 344, 205–212. [Google Scholar] [CrossRef]
- Sadat-Shojai, M.; Ershad-Langroudi, A. Polymeric coatings for protection of historic monuments: Opportunities and challenges. J. Appl. Polym. Sci. 2009, 112, 2535–2551. [Google Scholar] [CrossRef]
- Piacenti, F.; Camaiti, M. Synthesis and characterization of fluorinated polyetheric amides. J. Fluor. Chem. 1994, 68, 227–235. [Google Scholar] [CrossRef]
- Cao, Y.; Salvini, A.; Camaiti, M. Oligoamide grafted with perfluoropolyether blocks: A potential protective coating for stone materials. Prog. Org. Coat. 2017, 111, 164–174. [Google Scholar] [CrossRef]
- Gao, J.; Li, C.; Lv, Z.; Wang, R.; Wu, D.; Li, X. Correlation between the surface ageing of acrylic polyurethane coatings and environmental factors. Prog. Org. Coat. 2019, 132, 362–369. [Google Scholar] [CrossRef]
- Zhang, S.F.; Wang, R.M.; He, Y.F.; Song, P.F.; Wu, Z.M. Waterborne polyurethane-acrylic copolymers crosslinked core-shell nanoparticles for humidity-sensitive coatings. Prog. Org. Coat. 2013, 76, 729–735. [Google Scholar] [CrossRef]
- Alshammari, N.A.H.; Bakhotmah, D.A. Synthesis, reactivity, antimicrobial, and anti-biofilm evaluation of fluorinated 4-amino-3-mercapto-1,2,4-triazin-5(4H)-one and their derivatives. Phosphorus Sulfur. Silicon Relat. Elem. 2022, 198, 385–396. [Google Scholar] [CrossRef]
- Ahmad, W.; Jaiswal, K.K.; Soni, S. Green synthesis of titanium dioxide (TiO2) nanoparticles by using Mentha arvensis leaves extract and its antimicrobial properties. Inorg. Nano-Met. Chem. 2020, 50, 1032–1038. [Google Scholar] [CrossRef]
- Subhapriya, S.; Gomathipriya, P. Green synthesis of titanium dioxide (TiO2) nanoparticles by Trigonella foenum-graecum extract and its antimicrobial properties. Microb. Pathog. 2018, 116, 215–220. [Google Scholar] [CrossRef]
- Calia, A.; Lettieri, M.; Masieri, M.; Pal, S.; Licciulli, A.; Arima, V. Limestones coated with photocatalytic TiO2 to enhance building surface with self-cleaning and depolluting abilities. J. Clean. Prod. 2017, 165, 1036–1047. [Google Scholar] [CrossRef]
- Calia, A.; Lettieri, M.; Masieri, M. Durability assessment of nanostructured TiO2 coatings applied on limestones to enhance building surface with self-cleaning ability. Build. Environ. 2016, 110, 1–10. [Google Scholar] [CrossRef]
- Matteucci, E.; Scarcella, A.V.; Croveri, P.; Marengo, A.; Borghi, A.; Benelli, C.; Hamdan, O.; Favero-Longo, S.E. Lichens and other lithobionts on the carbonate rock surfaces of the heritage site of the tomb of Lazarus (Palestinian territories): Diversity, biodeterioration and control issues in a semi-arid environment. Ann. Microbiol. 2019, 69, 1033–1046. [Google Scholar] [CrossRef]
- Quagliarini, E.; Graziani, L.; Diso, D.; Licciulli, A.; D’Orazio, M. Is nano-TiO2 alone an effective strategy for the maintenance of stones in Cultural Heritage? J. Cult. Herit. 2018, 30, 81–91. [Google Scholar] [CrossRef]
- de los Ríos, A.; Pérez-Ortega, S.; Wierzchos, J.; Ascaso, C. Differential effects of biocide treatments on saxicolous communities: Case study of the Segovia cathedral cloister (Spain). Int. Biodeter. Biodegr. 2012, 67, 64–72. [Google Scholar] [CrossRef]
- Cámara, B.; de los Ríos, A.; Urizal, M.; Álvarez de Buergo, M.; Varas, M.J.; Fort, R.; Ascaso, C. Characterizing the microbial colonization of a dolostone quarry: Implications for stone biodeterioration and response to biocide treatments. Microb. Ecol. 2011, 62, 299–312. [Google Scholar] [CrossRef]
) not coated; (
) coating 1 (microemulsion based on modified silanes and siloxanes); (
) coating 2 (microemulsion based on nanosilanes, siloxanes, and C6 fluorinated compounds); (
) coating 3 (aqueous suspension of TiO2 dispersed in an acrylic polymer); (
) coating 4 (waterproofing based on modified silanes and siloxanes and C6 fluorinated compounds, with polyurethane).
) not coated; (
) coating 1 (microemulsion based on modified silanes and siloxanes); (
) coating 2 (microemulsion based on nanosilanes, siloxanes, and C6 fluorinated compounds); (
) coating 3 (aqueous suspension of TiO2 dispersed in an acrylic polymer); (
) coating 4 (waterproofing based on modified silanes and siloxanes and C6 fluorinated compounds, with polyurethane).


| Coating | Composition | Antimicrobial Properties | Dilution | Application Guidelines |
|---|---|---|---|---|
| 1 | Microemulsion based on modified silanes and siloxanes | Highly resistant to the action of fungi and microorganisms | 1:14 in tap water | Two or three applications with the paint roller, without drying between applications |
| 2 | Microemulsion based on nanosilanes, siloxanes, and C6 fluorinated compounds | Highly resistant to the action of fungi and microorganisms | 1:10 in tap water | Two or three applications in the same direction. After drying, carry out a similar application |
| 3 | Aqueous suspension of TiO2 dispersed in an acrylic polymer | Resistant against the action of fungi and microorganisms | 1:10 in tap water | One single application |
| 4 | Waterproofing based on modified silanes and siloxanes and C6 fluorinated compounds, with polyurethane | No information | 1:3 1st application; 1:2 2nd application; 1:1 3rd application; All in tap water | Two to four hours of drying after the first application; drying for one day after the second application |
| Commercial Name | Open Porosity (%) | Chemical Composition (*1) | Macroscopic Appearance |
|---|---|---|---|
| Azul Mónica lithotype A (limestone) | 1.4 | CaO 53.97%; MgO 1.15%; SiO2 2.37%; K2O 0.12%; Na2O 0.06; Al2O3 0.35%; Fe2O3 0.15%; TiO2 0.02%; LOI (*2) 42.72% | ![]() |
| Branco Real lithotype B (limestone) | 13.3 | CaO 55.97%; MgO 1.27%; SiO2 0.72%; K2O 0.12%; Na2O 0.07; Al2O3 0.07%; Fe2O3 0.04%; TiO2 0.01%; LOI 43.46% | ![]() |
| Rosa JPL lithotype C (marble) | 0.2 | CaO 55.22%; MgO 1.52%; SiO2 1.10%; K2O 0.17%; Na2O 0.09; Al2O3 0.09%; Fe2O3 0.26%; TiO2 0.01%; LOI 43.27% | ![]() |
| Golden Brown lithotype D (marble) | 0.3 | CaO 55.74%; MgO 1.99%; SiO2 1.59%; K2O 0.16%; Na2O 0.06; Al2O3 0.14%; Fe2O3 0.26%; TiO2 0.01%; LOI 41.32% | ![]() |
| Ardósia de Valongo lithotype E (slate) | 1.2 | CaO 0.44%; MgO 3.72%; SiO2 45.05%; K2O 3.96%; Na2O 1.42; Al2O3 31.71%; Fe2O3 8.60%; TiO2 1.43%; LOI 5.81% | ![]() |
| Macroscopic Features | Microscopic Features | Closest Related Strain on Basis of 16S and 18S rRNA Genes and ITS | Phylum |
|---|---|---|---|
![]() | ![]() | Bacillus sp. | Firmicutes |
![]() | ![]() | Arthrobacter sp. | Actinobacteria |
![]() | ![]() | Phoma sp. | Ascomycota |
![]() | ![]() | Cladosporium sp. | Ascomycota |
![]() | ![]() | Schizophyllum sp. | Basidiomycota |
![]() | ![]() | Saccharomyces sp. | Ascomycota |
| Microorganism | Coating 1 | Coating 2 | Coating 3 | Coating 4 | ||||||||
|---|---|---|---|---|---|---|---|---|---|---|---|---|
| 1:5 | 1:10 | 1:15 | 1:5 | 1:10 | 1:15 | 1:5 | 1:10 | 1:15 | 1:1 | 1:2 | 1:3 | |
| Bacillus sp. | 8.8 | 7.7 | 8.3 | 24.2 | 20.5 | 15 | 6.5 | 6.5 | 6.5 | 6.5 | 6.5 | 6.5 |
| Arthrobacter sp. | 8.8 | 6.8 | 8.2 | 21 | 17.3 | 17.3 | 6.5 | 6.5 | 6.5 | 6.5 | 6.5 | 6.5 |
| Phoma sp. | 6.5 | 6.5 | 6.5 | 23.2 | 21.5 | 21.3 | 6.5 | 6.5 | 6.5 | 6.5 | 6.5 | 6.5 |
| Cladosporium sp. | 6.5 | 6.5 | 6.5 | 21.8 | 21 | 18 | 0 | 6.5 | 6.5 | 6.5 | 0 | 0 |
| Schizophyllum sp. | 6.5 | 6.5 | 0 | 19.8 | 14 | 17 | 0 | 0 | 0 | 0 | 0 | 0 |
| Saccharomyces sp. | 6.5 | 6.5 | 6.5 | 22.5 | 21.8 | 23.7 | 6.5 | 6.5 | 6.5 | 6.5 | 6.5 | 6.5 |
Disclaimer/Publisher’s Note: The statements, opinions and data contained in all publications are solely those of the individual author(s) and contributor(s) and not of MDPI and/or the editor(s). MDPI and/or the editor(s) disclaim responsibility for any injury to people or property resulting from any ideas, methods, instructions or products referred to in the content. |
© 2023 by the authors. Licensee MDPI, Basel, Switzerland. This article is an open access article distributed under the terms and conditions of the Creative Commons Attribution (CC BY) license (https://creativecommons.org/licenses/by/4.0/).
Share and Cite
Dias, L.; Nunes, R.; Costa, M.; Caldeira, A.T.; Mirão, J.; Barrulas, P. Unveiling the Effectiveness of Innovative Commercial Coatings Used for the Preservation of Natural Stone—A Contribution. Heritage 2023, 6, 6328-6342. https://doi.org/10.3390/heritage6090331
Dias L, Nunes R, Costa M, Caldeira AT, Mirão J, Barrulas P. Unveiling the Effectiveness of Innovative Commercial Coatings Used for the Preservation of Natural Stone—A Contribution. Heritage. 2023; 6(9):6328-6342. https://doi.org/10.3390/heritage6090331
Chicago/Turabian StyleDias, Luís, Ricardo Nunes, Mafalda Costa, Ana Teresa Caldeira, José Mirão, and Pedro Barrulas. 2023. "Unveiling the Effectiveness of Innovative Commercial Coatings Used for the Preservation of Natural Stone—A Contribution" Heritage 6, no. 9: 6328-6342. https://doi.org/10.3390/heritage6090331
APA StyleDias, L., Nunes, R., Costa, M., Caldeira, A. T., Mirão, J., & Barrulas, P. (2023). Unveiling the Effectiveness of Innovative Commercial Coatings Used for the Preservation of Natural Stone—A Contribution. Heritage, 6(9), 6328-6342. https://doi.org/10.3390/heritage6090331